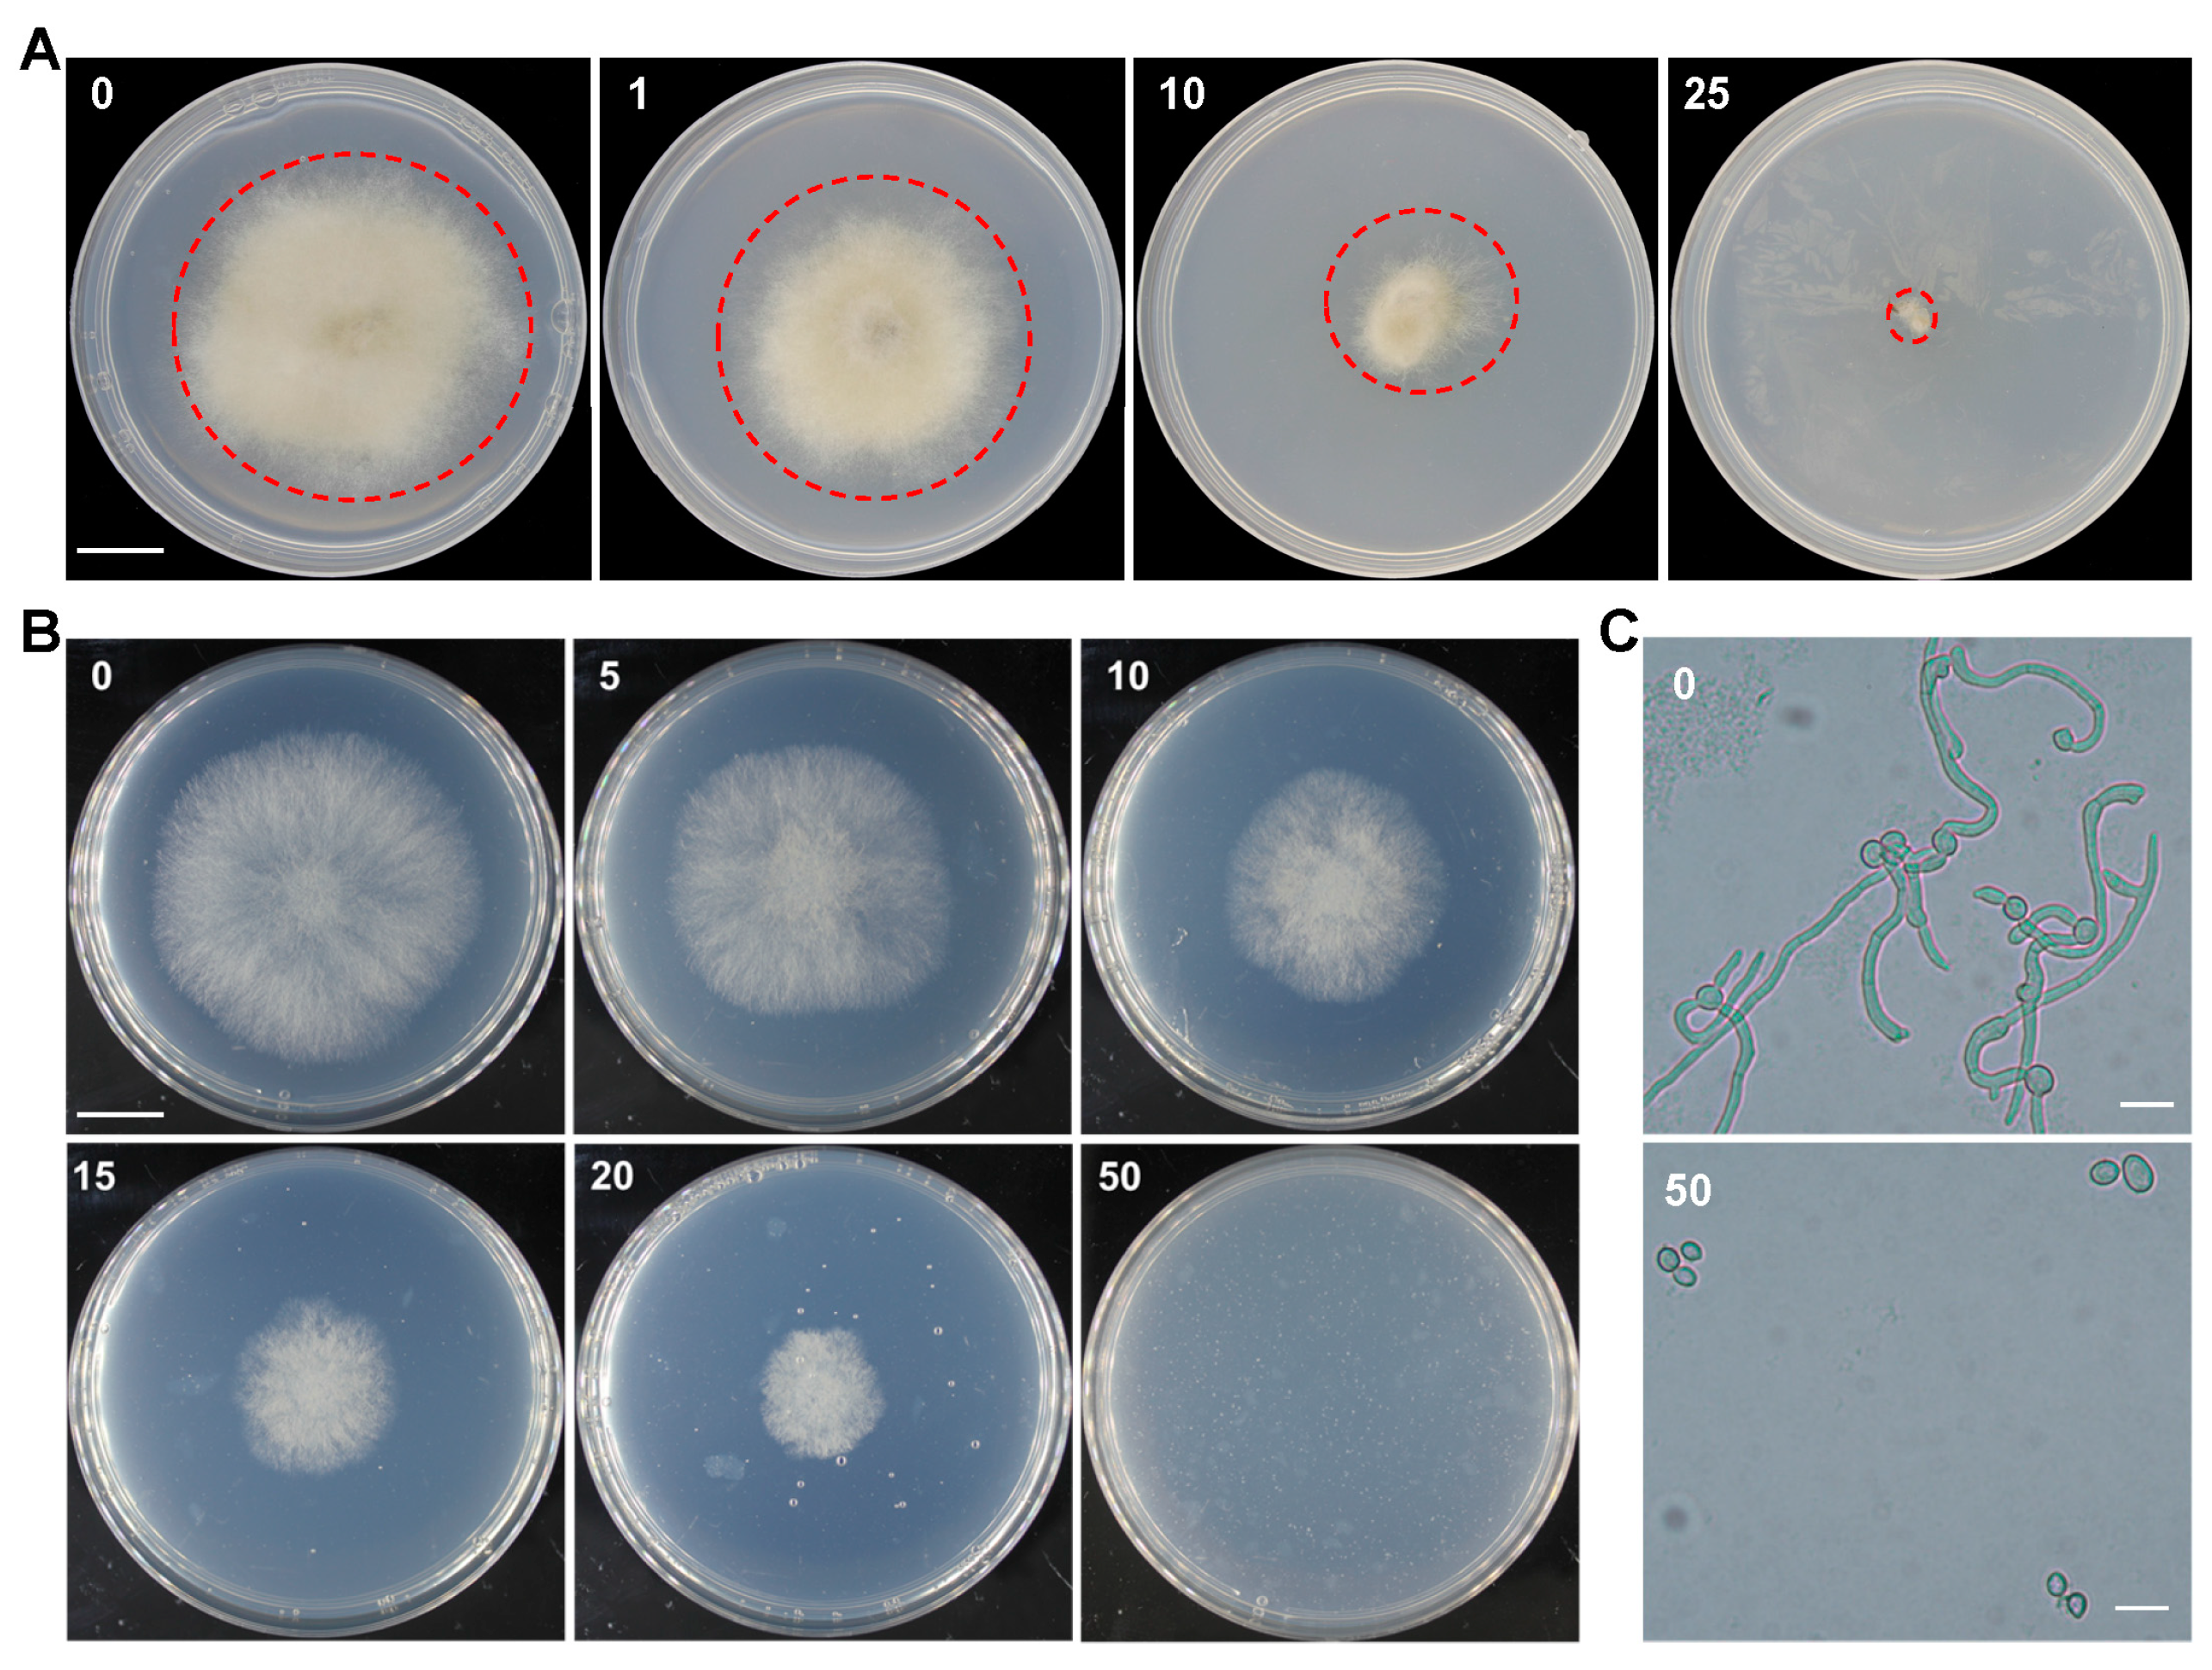
Plants 13 00324 g001

Codon Optimization Enables the Geneticin Resistance Gene to Be Applied Efficiently to the Genetic Manipulation of the Plant Pathogenic Fungus Botrytis cinerea
Abstract
1. Introduction
2. Results
2.1. Sensitivity Test of B. cinerea to Geneticin
2.2. Codon Optimization of the Geneticin Resistance Gene NPTII Based on the Codon Usage Preference of B. cinerea
2.3. The Codon-Optimized Gene BcNPTII Significantly Enhances the Transformation Efficiency of B. cinerea under the Selection Pressure of Geneticin
2.4. The Codon-Optimized Gene BcNPTII Can Be Used for Gene Double Knockout in B. cinerea, Even Using a Field Wild-Type Strain
3. Discussion
4. Materials and Methods
4.1. Botrytis cinerea Strains and Culture Conditions
4.2. Synthesis of the Codon-Optimized Geneticin Resistance Gene and Construction of the Random Insertion Binary Vector
4.3. Construction of the Knockout Vector
4.4. Genetic Transformation of B. cinerea
4.5. Molecular Analysis of Transformants
4.6. Sensitivity Analysis of B. cinerea to Geneticin
Supplementary Materials
Author Contributions
Funding
Data Availability Statement
Acknowledgments
Conflicts of Interest
References
- Fillinger, S.; Elad, Y. Botrytis—The Fungus, the Pathogen and Its Management in Agricultural Systems; Springer: New York, NY, USA, 2016. [Google Scholar] [CrossRef]
- Williamson, B.; Tudzynski, B.; Tudzynski, P.; van Kan, J.A. Botrytis cinerea: The cause of grey mould disease. Mol. Plant Pathol. 2007, 8, 561–580. [Google Scholar] [CrossRef] [PubMed]
- Weiberg, A.; Wang, M.; Lin, F.M.; Zhao, H.; Zhang, Z.; Kaloshian, I.; Huang, H.D.; Jin, H. Fungal small RNAs suppress plant immunity by hijacking host RNA interference pathways. Science 2013, 342, 118–123. [Google Scholar] [CrossRef] [PubMed]
- Veloso, J.; van Kan, J.A.L. Many Shades of Grey in Botrytis-Host Plant Interactions. Trends Plant Sci. 2018, 23, 613–622. [Google Scholar] [CrossRef] [PubMed]
- Dean, R.; Van Kan, J.A.; Pretorius, Z.A.; Hammond-Kosack, K.E.; Di Pietro, A.; Spanu, P.D.; Rudd, J.J.; Dickman, M.; Kahmann, R.; Ellis, J.; et al. The Top 10 fungal pathogens in molecular plant pathology. Mol. Plant Pathol. 2012, 13, 414–430. [Google Scholar] [CrossRef] [PubMed]
- Petrasch, S.; Knapp, S.J.; van Kan, J.A.L.; Blanco-Ulate, B. Grey mould of strawberry, a devastating disease caused by the ubiquitous necrotrophic fungal pathogen Botrytis cinerea. Mol. Plant Pathol. 2019, 20, 877–892. [Google Scholar] [CrossRef] [PubMed]
- Choquer, M.; Rascle, C.; Goncalves, I.R.; de Vallee, A.; Ribot, C.; Loisel, E.; Smilevski, P.; Ferria, J.; Savadogo, M.; Souibgui, E.; et al. The infection cushion of Botrytis cinerea: A fungal ‘weapon’ of plant-biomass destruction. Environ. Microbiol. 2021, 23, 2293–2314. [Google Scholar] [CrossRef] [PubMed]
- Choquer, M.; Fournier, E.; Kunz, C.; Levis, C.; Pradier, J.M.; Simon, A.; Viaud, M. Botrytis cinerea virulence factors: New insights into a necrotrophic and polyphageous pathogen. FEMS Microbiol. Lett. 2007, 277, 1–10. [Google Scholar] [CrossRef]
- Liu, L.; Gueguen-Chaignon, V.; Goncalves, I.R.; Rascle, C.; Rigault, M.; Dellagi, A.; Loisel, E.; Poussereau, N.; Rodrigue, A.; Terradot, L.; et al. A secreted metal-binding protein protects necrotrophic phytopathogens from reactive oxygen species. Nat. Commun. 2019, 10, 4853. [Google Scholar] [CrossRef]
- Amselem, J.; Cuomo, C.A.; van Kan, J.A.; Viaud, M.; Benito, E.P.; Couloux, A.; Coutinho, P.M.; de Vries, R.P.; Dyer, P.S.; Fillinger, S.; et al. Genomic analysis of the necrotrophic fungal pathogens Sclerotinia sclerotiorum and Botrytis cinerea. PLoS Genet. 2011, 7, e1002230. [Google Scholar] [CrossRef]
- Feng, H.Q.; Li, G.H.; Du, S.W.; Yang, S.; Li, X.Q.; de Figueiredo, P.; Qin, Q.M. The septin protein Sep4 facilitates host infection by plant fungal pathogens via mediating initiation of infection structure formation. Environ. Microbiol. 2017, 19, 1730–1749. [Google Scholar] [CrossRef]
- Qin, S.; Veloso, J.; Baak, M.; Boogmans, B.; Bosman, T.; Puccetti, G.; Shi-Kunne, X.; Smit, S.; Grant-Downton, R.; Leisen, T.; et al. Molecular characterization reveals no functional evidence for naturally occurring cross-kingdom RNA interference in the early stages of Botrytis cinerea-tomato interaction. Mol. Plant Pathol. 2023, 24, 3–15. [Google Scholar] [CrossRef] [PubMed]
- Sun, J.; Sun, C.H.; Chang, H.W.; Yang, S.; Liu, Y.; Zhang, M.Z.; Hou, J.; Zhang, H.; Li, G.H.; Qin, Q.M. Cyclophilin BcCyp2 Regulates Infection-Related Development to Facilitate Virulence of the Gray Mold Fungus Botrytis cinerea. Int. J. Mol. Sci. 2021, 22, 1694. [Google Scholar] [CrossRef] [PubMed]
- Leisen, T.; Bietz, F.; Werner, J.; Wegner, A.; Schaffrath, U.; Scheuring, D.; Willmund, F.; Mosbach, A.; Scalliet, G.; Hahn, M. CRISPR/Cas with ribonucleoprotein complexes and transiently selected telomere vectors allows highly efficient marker-free and multiple genome editing in Botrytis cinerea. PLoS Pathog. 2020, 16, e1008326. [Google Scholar] [CrossRef] [PubMed]
- Bhadauria, V.; Banniza, S.; Vandenberg, A.; Selvaraj, G.; Wei, Y. Peroxisomal alanine: Glyoxylate aminotransferase AGT1 is indispensable for appressorium function of the rice blast pathogen, Magnaporthe oryzae. PLoS ONE 2012, 7, e36266. [Google Scholar] [CrossRef] [PubMed][Green Version]
- Kim, S.; Park, S.Y.; Kim, K.S.; Rho, H.S.; Chi, M.H.; Choi, J.; Park, J.; Kong, S.; Park, J.; Goh, J.; et al. Homeobox transcription factors are required for conidiation and appressorium development in the rice blast fungus Magnaporthe oryzae. PLoS Genet. 2009, 5, e1000757. [Google Scholar] [CrossRef]
- Nguyen, Q.B.; Kadotani, N.; Kasahara, S.; Tosa, Y.; Mayama, S.; Nakayashiki, H. Systematic functional analysis of calcium-signaling proteins in the genome of the rice-blast fungus, Magnaporthe oryzae, using a high-throughput RNA-silencing system. Mol. Microbiol. 2008, 68, 1348–1365. [Google Scholar] [CrossRef] [PubMed]
- Leroch, M.; Mernke, D.; Koppenhoefer, D.; Schneider, P.; Mosbach, A.; Doehlemann, G.; Hahn, M. Living colors in the gray mold pathogen Botrytis cinerea: Codon-optimized genes encoding green fluorescent protein and mCherry, which exhibit bright fluorescence. Appl. Environ. Microbiol. 2011, 77, 2887–2897. [Google Scholar] [CrossRef]
- Pinedo, C.; Wang, C.M.; Pradier, J.M.; Dalmais, B.; Choquer, M.; Le Pecheur, P.; Morgant, G.; Collado, I.G.; Cane, D.E.; Viaud, M. Sesquiterpene synthase from the botrydial biosynthetic gene cluster of the phytopathogen Botrytis cinerea. ACS Chem. Biol. 2008, 3, 791–801. [Google Scholar] [CrossRef]
- Dalmais, B.; Schumacher, J.; Moraga, J.; Le Pêcheur, P.; Tudzynski, B.; Collado, I.G.; Viaud, M. The Botrytis cinerea phytotoxin botcinic acid requires two polyketide synthases for production and has a redundant role in virulence with botrydial. Mol. Plant Pathol. 2011, 12, 564–579. [Google Scholar] [CrossRef]
- Han, Y.; Joosten, H.J.; Niu, W.L.; Zhao, Z.M.; Mariano, P.S.; McCalman, M.; van Kan, J.; Schaap, P.J.; Dunaway-Mariano, D. Oxaloacetate hydrolase, the C-C bond lyase of oxalate secreting fungi. J. Biol. Chem. 2007, 282, 9581–9590. [Google Scholar] [CrossRef]
- Liu, X.; Wang, X.; Wang, L.; Shu, Q.; Cao, Z. Generation of green fluorescent protein vector transformed Paecilomyces lilacinus Strains. Afr. J. Microbiol. Res. 2013, 7, 1114–1120. [Google Scholar]
- Ayad-Durieux, Y.; Knechtle, P.; Goff, S.; Dietrich, F.; Philippsen, P. A PAK-like protein kinase is required for maturation of young hyphae and septation in the filamentous ascomycete Ashbya gossypii. J. Cell Sci. 2000, 113, 4563–4575. [Google Scholar] [CrossRef] [PubMed]
- Namiki, F.; Matsunaga, M.; Okuda, M.; Inoue, I.; Nishi, K.; Fujita, Y.; Tsuge, T. Mutation of an arginine biosynthesis gene causes reduced pathogenicity in Fusarium oxysporum f. sp. melonis. Mol. Plant Microbe Interact. 2001, 14, 580–584. [Google Scholar] [CrossRef] [PubMed]
- Hahn, M.; Scalliet, G. One Cut to Change Them All: CRISPR/Cas, a Groundbreaking Tool for Genome Editing in Botrytis cinerea and Other Fungal Plant Pathogens. Phytopathology 2021, 111, 474–477. [Google Scholar] [CrossRef] [PubMed]
- Quidde, T.; Osbourn, A.E.; Tudzynski, P. Detoxification of α-tomatine by Botrytis cinerea. Physiol. Mol. Plant Pathol. 1998, 52, 151–165. [Google Scholar] [CrossRef]
- Mullins, E.D.; Chen, X.; Romaine, P.; Raina, R.; Geiser, D.M.; Kang, S. Agrobacterium-Mediated Transformation of Fusarium oxysporum: An Efficient Tool for Insertional Mutagenesis and Gene Transfer. Phytopathology 2001, 91, 173–180. [Google Scholar] [CrossRef]
- Cao, S.N.; Yuan, Y.; Qin, Y.H.; Zhang, M.Z.; de Figueiredo, P.; Li, G.H.; Qin, Q.M. The pre-rRNA processing factor Nop53 regulates fungal development and pathogenesis via mediating production of reactive oxygen species. Environ. Microbiol. 2018, 20, 1531–1549. [Google Scholar] [CrossRef]
- Liu, J.K.; Chang, H.W.; Liu, Y.; Qin, Y.; Ding, Y.H.; Wang, L.; Zhao, Y.; Zhang, M.Z.; Cao, S.N.; Li, L.T.; et al. The key gluconeogenic gene is crucial for virulence of Botrytis cinerea via initiating its conidia germination and host penetration. Environ. Microbiol. 2018, 20, 1794–1814. [Google Scholar] [CrossRef]
- Chi, M.H.; Park, S.Y.; Lee, Y.H. A Quick and Safe Method for Fungal DNA Extraction. Plant Pathol. J. 2009, 25, 108–111. [Google Scholar] [CrossRef]

| Strain | Description | Source |
|---|---|---|
| B05.10 | Wild-type strain | [26] |
| CLS1 | A Chinese field strain (Wild-type strain) | This study |
| N2 | NPTII random insertion in B05.10 | This study |
| N4 | NPTII random insertion in B05.10 | This study |
| B7 | BcNPTII random insertion in B05.10 | This study |
| B9 | BcNPTII random insertion in B05.10 | This study |
| ΔoahA | BcOAHA gene knockout (ΔBcoahA::HPH) in CLS1 | This study |
| ΔoahA Δbot2 | Double gene knockout (ΔBcoahA::HPH; ΔBcbot2::BcNPTII) in CLS1 | This study |
| Vector | Description | Source |
|---|---|---|
| pXEH | Binary vector used for knockout of fungal genes, containing the HPH gene within its T-DNA region; KmR | [11] |
| pXEG | Binary vector used for knockout of fungal genes, containing the NPTII gene within its T-DNA region; KmR | This study |
| pXEGbc | Binary vector used for knockout of fungal genes, containing the BcNPTII gene within its T-DNA region; KmR | This study |
| pBOT2-ko | Binary vector used for knockout of BcBOT2, containing the BcNPTII gene within its T-DNA region; KmR | This study |
| Name | Sequence (5′–3′) |
|---|---|
| For identification of BcNPTII | |
| GbF | GGCACAACAGACAATCGG |
| GbR | ATCACGGGTAGCCAAAGC |
| For construction of the BOT2 knockout vector | |
| BOT2-UP-F | tgggaattcgagctcggtacAGGTCCTGTTGACATGGAATC |
| BOT2-UP-R | agtcgacctgcaggcatgcaCGGAACACGAACGAATGG |
| BOT2-DN-F | ccttcaatatcagttggtacTGGGCTAAGCACAGGACAATG |
| BOT2-DN-R | aatgcggctccacagctgcaCCTCCCGATGATAAGGGTTC |
| For Screening the BOT2 knockout strains | |
| NU | TGGACAACCTTGAGGACGAG |
| ND | GCGGAGTTGCCTTGGAGT |
| GbF-RC | CCGATTGTCTGTTGTGCC |
| GbR-RC | GCTTTGGCTACCCGTGAT |
| For identification of BOT2 | |
| BOT2-F | GACTGGAATCATTGGGTTTG |
| BOT2-R | GCGTTTGTGCTGGTCTATC |
| For identification of BOA6 (to confirm the genomic DNAs of transformants were suitable for amplification) | |
| BOA6-F | AACTCGGCAATCGAACCT |
| BOA6-R | GCAGCATAAGCAGCACCA |
Disclaimer/Publisher’s Note: The statements, opinions and data contained in all publications are solely those of the individual author(s) and contributor(s) and not of MDPI and/or the editor(s). MDPI and/or the editor(s) disclaim responsibility for any injury to people or property resulting from any ideas, methods, instructions or products referred to in the content. |
© 2024 by the authors. Licensee MDPI, Basel, Switzerland. This article is an open access article distributed under the terms and conditions of the Creative Commons Attribution (CC BY) license (https://creativecommons.org/licenses/by/4.0/).
Share and Cite
Tang, M.; Wang, Y.; Wang, K.; Zhou, Y.; Zhao, E.; Zhang, H.; Zhang, M.; Yu, H.; Zhao, X.; Li, G. Codon Optimization Enables the Geneticin Resistance Gene to Be Applied Efficiently to the Genetic Manipulation of the Plant Pathogenic Fungus Botrytis cinerea. Plants 2024, 13, 324. https://doi.org/10.3390/plants13020324
Tang M, Wang Y, Wang K, Zhou Y, Zhao E, Zhang H, Zhang M, Yu H, Zhao X, Li G. Codon Optimization Enables the Geneticin Resistance Gene to Be Applied Efficiently to the Genetic Manipulation of the Plant Pathogenic Fungus Botrytis cinerea. Plants. 2024; 13(2):324. https://doi.org/10.3390/plants13020324
Chicago/Turabian StyleTang, Maoyao, Yangyizhou Wang, Kexin Wang, Yuanhang Zhou, Enshuang Zhao, Hao Zhang, Mingzhe Zhang, Hang Yu, Xi Zhao, and Guihua Li. 2024. "Codon Optimization Enables the Geneticin Resistance Gene to Be Applied Efficiently to the Genetic Manipulation of the Plant Pathogenic Fungus Botrytis cinerea" Plants 13, no. 2: 324. https://doi.org/10.3390/plants13020324
APA StyleTang, M., Wang, Y., Wang, K., Zhou, Y., Zhao, E., Zhang, H., Zhang, M., Yu, H., Zhao, X., & Li, G. (2024). Codon Optimization Enables the Geneticin Resistance Gene to Be Applied Efficiently to the Genetic Manipulation of the Plant Pathogenic Fungus Botrytis cinerea. Plants, 13(2), 324. https://doi.org/10.3390/plants13020324

